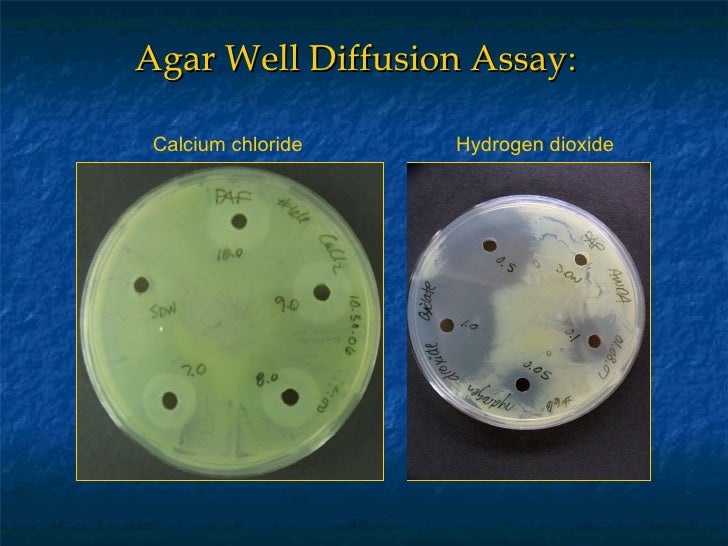

Agar Well Diffusion Of Honey
Aureus with 5% (w/v) mic and mbc of 6.25%. Thereafter, the inhibition zone diameters (izd), denoting the potency of the natural honey against the clinical bacterial isolates was measured in duplicates.
The agar well diffusion method was used for an initial screening of honey samples, as performed by allen et al, with slight adjustments. Three commercial honey samples from apis sp.
Agar Well Diffusion Of Honey. Diffuser is an instrument that is commonly owned by aromatherapy lovers. There are many types and functions of diffusers on the market, according to the needs of the users. Be sure that you're right in selecting a diffuser so that the benefits of aromatherapy are felt to the maximum.
A diffuser is a tool which converts aromatic oils to fragrant vapors, and then distribute them throughout the air so that they're easier to breathe. The use of a diffuser in a room can create a relaxing and comfortable environment. This is why the use of diffusers is a great way to relax the mind and ease anxiety.
Although the diffusion of air is beneficial, it is not proven appropriate for use as a method of the vaporization of antiseptic liquids to clean the air. This could lead to adverse consequences, including irritation of the respiratory tract as well as the eyes.
The use of diffusers to date has been useful for optimizing the advantages from essential oils. The diffused aroma enhances the sense of smell and affects emotions and your nervous system. But, it is contingent on the kind of aromatherapy
The use of a diffuser also known as a room humidifier, is now increasingly becoming a trend in the world of. It is typically filled with essential oils that can provide a cool and fresh aromatherapy. This way, not only the air is humid but also the ambience is more comfortable with a calming aroma of freshness.
In the midst of the trends that people are becoming more attracted to is the fact that the usage of a diffuser isn't just a way to add to the decor of a room. There are many health benefits of a diffuser that you can reap. Beginning with the launching of your digestive process, helping the body and mind to be more relaxed, to improving the mood and mood of a better day.
Not only that, the advantages of a diffuser may also overcome various skin-related health issues that commonly happen. Such as dry skin conditions that occur due to the environment's air quality isn't humid enough, which causes it to become dry, cold and damaging. If you suffer from this condition, using a diffuser to boost the humidity in the room can assist.